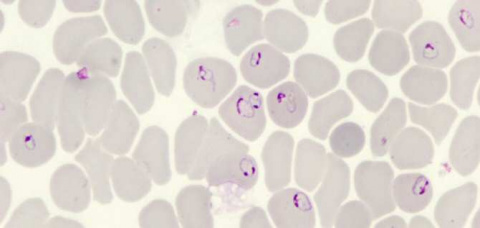

Medicina
Nanoparticles' movements reveal whether they can successfully target cancer
Noticia en inglés
Targeted drug-delivery systems hold significant promise for treating cancer effectively by sparing healthy surrounding tissues. But the promising approach can only work if the drug hits its target.
A Northwestern University research team has developed a new way to determine whether or not single drug-delivery nanoparticles will successfully hit their intended targets -- by simply analyzing each nanoparticle's distinct movements in real time.
By studying drug-loaded gold nanostars on cancer cell membranes, the researchers found that nanostars designed to target cancer biomarkers transited over larger areas and rotated much faster than their non-targeting counterparts. Even when surrounded by non-specifically adhered proteins, the targeting nanostars maintained their distinct, signature movements, suggesting that their targeting ability remains uninhibited.
"Moving forward, this information can be used to compare how different nanoparticle characteristics -- such as particle size, shape and surface chemistry -- can improve the design of nanoparticles as targeting, drug-delivery agents," said Northwestern's Teri Odom, who led the study.
The study published today (Aug. 9) in the journal ACS Nano. Odom is the Charles E. and Emma H. Morrison Professor of Chemistry in Northwestern's Weinberg College of Arts and Sciences.
![[Img #56618]](https://noticiasdelaciencia.com/upload/images/08_2019/4935_208414_web.jpg)
Gold nanostars have emerged as promising drug-delivery agents that can be designed to target cancer cells. (Credit: Teri Odom/Northwestern University)
The medical field has long been searching for alternatives to current cancer treatments, such as chemotherapy and radiation, which harm healthy tissues in addition to diseased cells. Although these are effective ways to treat cancer, they carry risks of painful or even dangerous side effects. By delivering drugs directly into the diseased area -- instead of blasting the whole body with treatment -- targeted delivery systems result in fewer side effects than current treatment methods.
"The selective delivery of therapeutic agents to cancer tumors is a major goal in medicine to avoid side effects," Odom said. "Gold nanoparticles have emerged as promising drug-delivery vehicles that can be synthesized with designer characteristics for targeting cancer cells."
Various proteins, however, tend to bind to nanoparticles when they enter the body. Researchers have worried that these proteins might impede the particles' targeting abilities. Odom and her team's new imaging platform can now screen engineered nanoparticles to determine if their targeting function is retained in the presence of the adhered proteins. (Fuente: Northwestern University)